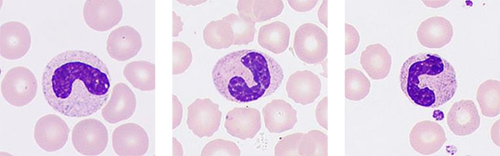
MC-80
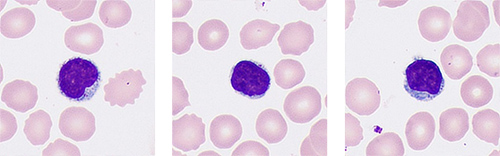
MC-80
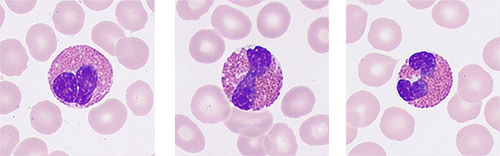
MC-80

MC-80 AUTOMATED DIGITAL CELL MORPHOLOGY ANALYZER
The MC-80 is taking digital morphology analysis to the next level, delivering clearer images which are able to capture abnormalities in more detail. With advanced algorithms, the analyzer enables better identification of different cells with high throughput, resulting in greater productivity.
|
More Clarity
Display the ultra clarity and authenticity of each cell
The high-performance objective and advanced image sensor offer ultra resolution images to reappear the real view under the microscope.
|
 |
|

Segmented neutrophils
Band neutrophils
|
Lymphocytes
Eosinophils
|
|

Basophils

Monocytes
|

Reactive Lymphocytes

Immature Granulocytes
|
|

Abnormal Lymphocytes

Blast cells
|

Promonocytes

Abnormal Promyelocytes
|
Capture comprehensive pathological features of each cell
|
Multilayer fusion technology
Simulate manual focus adjustment and accurately restore the pathological features of cells, which is helpful for early screening of blood diseases (such as acute promyelocytic leukemia) and infectious diseases.
|
|
More Intelligence
Reliable cell pre-classification and pre-characterization
 |
WBC
Accurately pre-classify white blood cells, especially for the abnormal cells, such as blast cells, reactive lymphocytes, etc.
|
|
RBC
Pre-characterized RBC morphology can be modified with one click.
|
|
|
PLT
Conveniently count and estimate platelets.
|
|

PLT counting assistance
|
High-speed FLY-MODE ensures accurate PLT clump
|
Intelligent analysis rules result in a smart process and less manual intervention

More Productivity

Diverse configurations to meet all kinds of demands
MC-80 opens a new chapter in hematology with Cellular Analysis Lines
|
CAL 6000
|
|

Width × Depth × Height : 2305 × 1030 × 810 (mm)
|

Width × Depth × Height : 2970 × 1030 × 810 (mm)
|
|
CAL 8000
|
|

Width × Depth × Height : 8240 × 1030 × 1470 (mm)
|